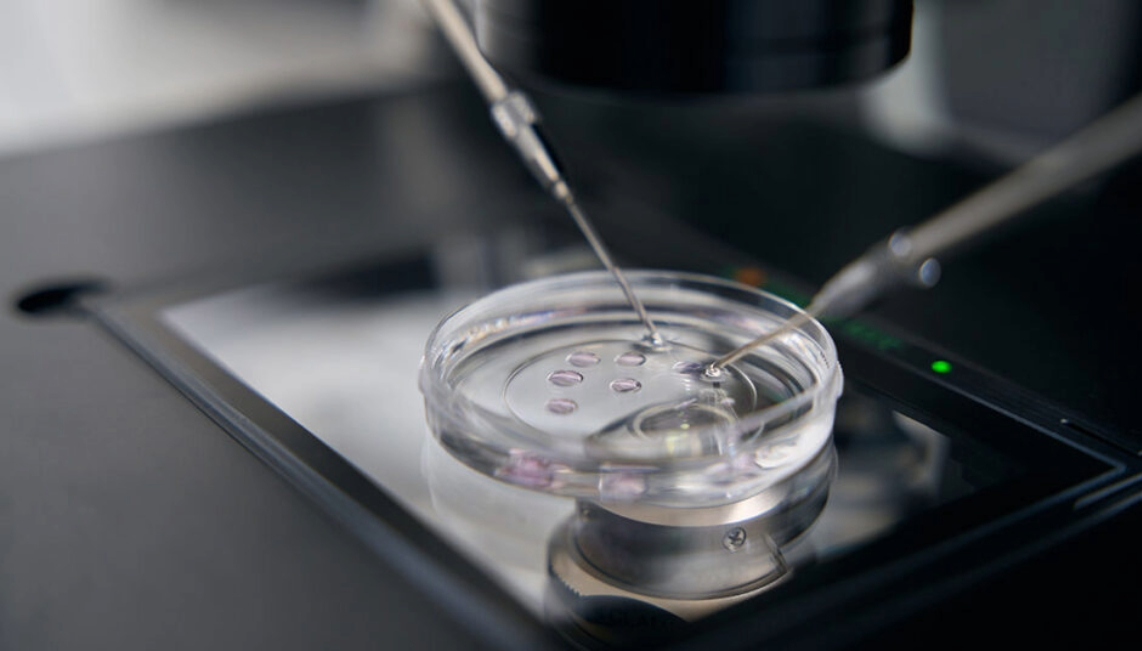

Mapa de laboratorios alternativos en Latinoamérica
Te invitamos a conocer a los laboratorios latinoamericanos que están revolucionando la forma en que hacemos ciencia.
La creciente innovación científica y tecnológica ha impulsado el desarrollo de métodos alternativos a la experimentación en animales, conocidos como NAMS, en sectores como la cosmética o biomedicina. Los NAMs permiten evaluar la seguridad y eficacia de productos con pruebas químicas, cultivos celulares y sistemas computacionales. Han sido validados y promovidos por organismos como la OCDE en Europa y la FDA en Estados Unidos. Además, el interés de muchos investigadores en capacitarse bajo los principios de las 3R refleja un mayor compromiso por mejorar la calidad de vida de los animales. Aquí, estos avances se consolidan a través de laboratorios que desarrollan, validan o aplican NAMs, como cultivos de córnea y piel humana para evaluar irritación y corrosión de químicos. Tenemos alternativas robustas y alineadas con estándares internacionales, que responden tanto a la presión social por productos libres de crueldad como al interés industrial por métodos económicos, rápidos y reproducibles. Además, se vuelven una ventaja, ya que adelantarse a regulaciones exigentes facilita procesos de exportación y validación sanitaria. Considerando estos avances, el equipo de Investigación de Te Protejo diseñó un mapa interactivo con laboratorios alternativos de Latinoamérica, para facilitar el acceso a ellos por parte de la industria cosmética y de aseo.
En esta investigación Brasil destacó como líder en el desarrollo de alternativas con al menos ocho laboratorios, una Red nacional de métodos alternativos (RENAMA) y un Centro de validación para métodos alternativos (BraCVAM). Le sigue Argentina con el centro CLAIM®, entidad pionera en el país en el uso de métodos alternativos desde 1999, trabajo que ha permitido construir una base científica que ha nutrido a toda la región, seguido de LMA y Bio Fucal, luego México con laboratorios como LIALT e ILAB, y finalmente Chile con los centros Functional Life y Rubisco Biotechnology.
Estos centros han logrado adaptar modelos de vanguardia sólo con tecnologías latinoamericanas y decidieron adoptar una cultura de cuidado y responsabilidad técnica. Este mapa se construye de la investigación documental y el contacto directo con los investigadores, para que la comunidad pueda explorar cuáles son los métodos disponibles y qué laboratorios los desarrollan. Fortalecer y visibilizar su trabajo implica avanzar a una investigación contextualizada en la realidad latinoamericana, que dialogue con nuestras prioridades sanitarias y sociales. También permite identificar ensayos que podrían complementarse o validarse, reduciendo costos y mejorando el cumplimiento normativo y avanzar a certificaciones con respaldo local, fortaleciendo la confianza del consumidor. Esta cartografía es una invitación a fortalecer la comunidad científica latinoamericana, si tu laboratorio ofrece ensayos alternativos, contáctanos y sé parte de este cambio.
Comparte:
Copiar URL Más posts de raquelAl enviar tus consultas o comentarios estás accediendo a recibir nuestro newsletter de forma mensual.



AGREGAR UN COMENTARIO